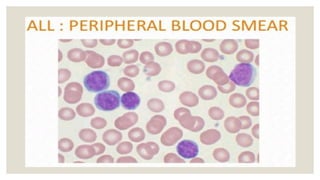

The document provides a comprehensive overview of acute lymphoblastic leukemia (ALL), detailing its classification, etiology, clinical presentation, and genetic abnormalities. It describes different morphological types of leukemia blasts, their immunophenotypes, and various classifications such as FAB, immunological, and WHO. The document emphasizes the importance of specific genetic mutations and cytogenetic alterations in the pathogenesis and prognosis of ALL.